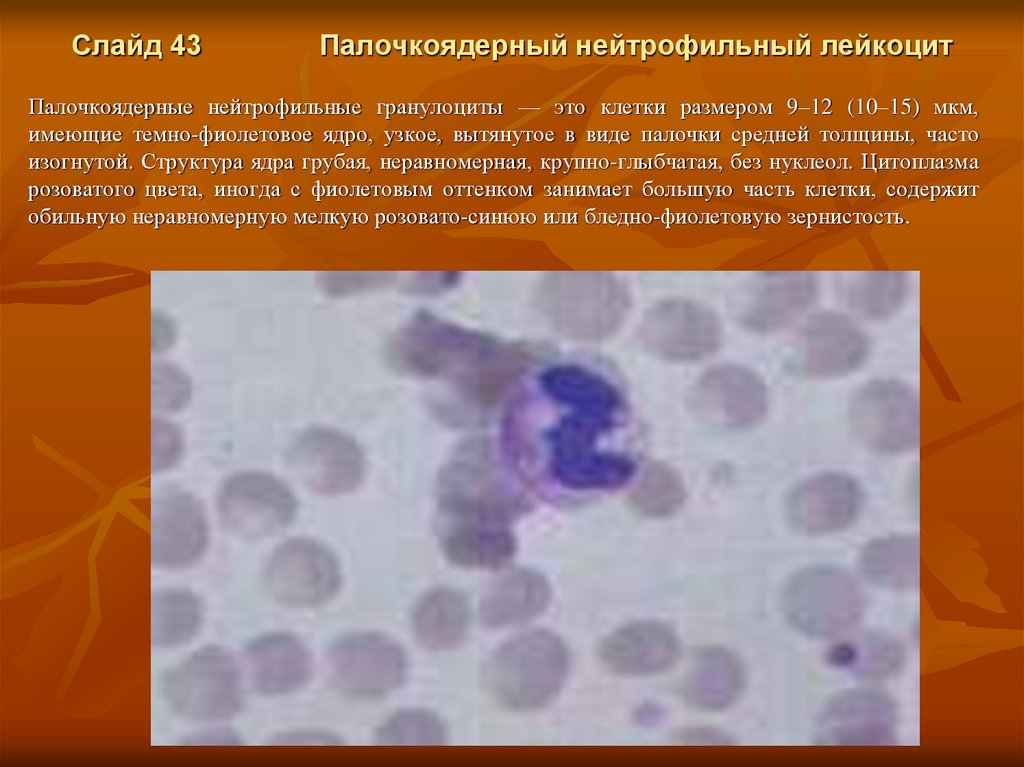
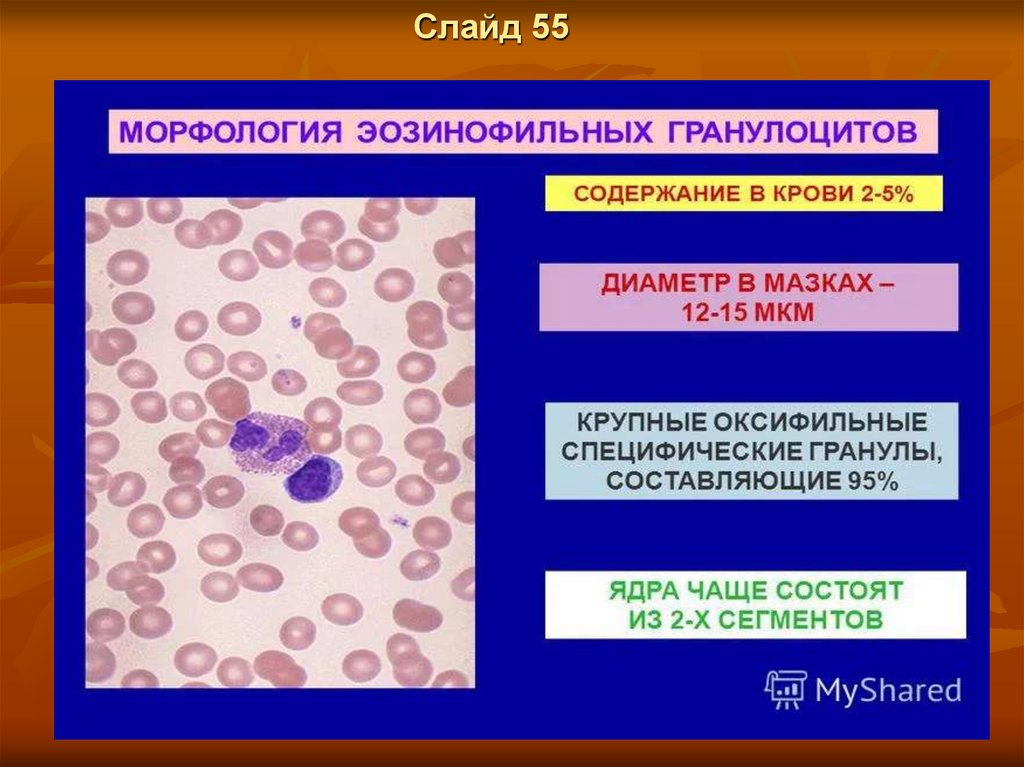
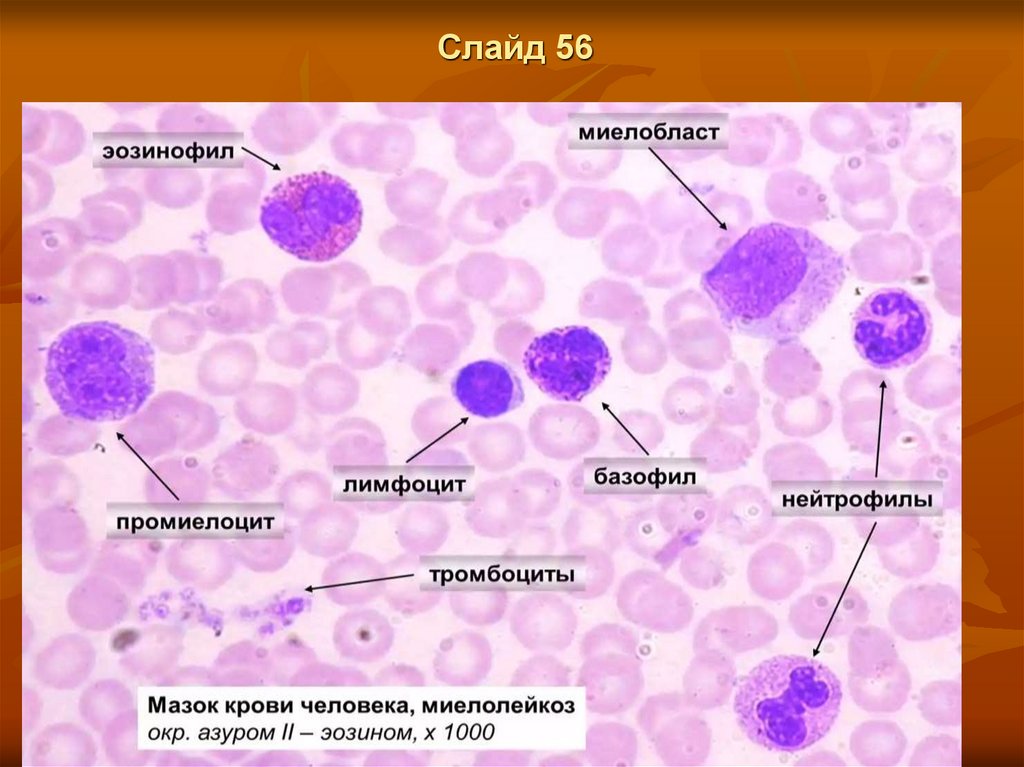

Похожие презентации:
Строение крови
1. Занятие 8 Тема: Строение крови
Цели и задачи:.1. Познакомиться со строением крови.
2. Познакомиться со строением форменных элементов крови.
Задание для самостоятельной работы студентов.
1.Зарисовать слайды: 12,26,30,38,65(1),71,74,78(1).
С остальными ознакомиться.
2. Ответить на вопросы для самоконтроля.
2.
Слайд 1Важнейшим компонентом внутренней среды организма является кровь.
Кровь - жидкая ткань организма, выполняющая жизненно-важные функции.
Советский исследователь-клиницист Г.Ф. Ланг в 1939 году выдвинул понятие «система крови».
Система крови – это совокупность органов кроветворения, периферической крови и органов
кроверазрушения.
Кровь - это ткань мезенхимного происхождения.
Проблемы физиологии клеток крови, кроветворения и гемостаза относятся к числу интенсивно
изучаемых в физиологии и других областях медицины.
Кровь - одна из интегрирующих систем организма. Различные отклонения в состоянии организма
и отдельных органов приводят к изменениям в системе крови и наоборот. Именно поэтому при
оценке состояния здоровья или нездоровья человека тщательно исследуют параметры,
характеризующие кровь (гематологические показатели).
Ежечасно у здорового человека разрушается и вновь образуется 20 миллиардов тромбоцитов, 10
миллиардов эритроцитов и 5 миллиардов лейкоцитов.
Примерно каждые 2 года в организме человека производится масса клеток крови, равная массе его
тела.
У взрослых мужчин объем циркулирующей в организме крови составляет 5–6 литров, у взрослых
женщин – 4–4,5 литра. При этом мужская кровь в норме богаче эритроцитами, так что для
переноса литра кислорода мужчине нужно меньше крови, чем женщине. Получается, что у
здорового мужчины крови больше, чем у здоровой женщины, к тому же используется этот объем
эффективнее.
Именно поэтому тяжелые физические нагрузки, при которых тканям требуется больше кислорода,
мужчинами переносятся легче.
3.
Слайд 2Функции крови
1. Транспортная функция – кровь переносит (транспортирует) различные вещества. Эта функция
включает в себя:
- дыхательную – перенос кислорода и углекислого газа.
- трофическую - перенос питательных веществ.
- экскреторную – транспорт конечных продуктов обмена веществ (мочевины, мочевой кислоты,
СО2 и др.), а также избыточной воды, минеральных и органических веществ к органам выделения
(почки, легкие, потовые железы).
- терморегуляторную – кровь транспортирует тепло от более нагретых органов к менее нагретым
и к органам теплоотдачи.
2. Защитная функция – включает в себя:
- иммунные реакции, т.е. кровь способна обезвреживать инородные тела и патогенные
микроорганизмы;
- гомеостаз – способность крови к свертыванию и к остановке кровотечения, а также к
поддержанию крови в жидком состоянии в норме.
3. Регуляторная функция – включает в себя:
- гуморальную регуляцию функций различных систем и тканей через доставку гормонов,
биологически активных веществ (БАВ) к клеткам организма;
- секрецию клетками крови БАВ.
4. Гомеостатическая функция – участие крови в поддержании постоянства внутренней среды
организма (например, постоянства рН, водно-солевого
обмена) и регенерации тканей.
4.
Слайд 3Цельная кровь состоит из жидкой части крови – плазмы – 54-64% (55-60%) и форменных
элементов – эритроцитов, лейкоцитов и тромбоцитов - 36-46% (40 - 45%).
Количество крови в организме составляет 6-8% от массы тела, то есть у человека массой 65-70
кг количество крови 4,5-5 литров. В состоянии покоя до 45-50% всей массы крови находится в
кровяных депо – селезенке, печени, легких и подкожном сосудистом сплетении.
5.
Слайд 4Плазма крови
6.
Слайд 57.
Слайд 6Плазма крови.
Плазма крови состоит из воды (90-92%) и сухого остатка (8 -10%).
Сухой остаток представлен:
1. Органическими соединениями.
Из них:
а) белки - 7-8%;
б) остаточный азот в составе аммиака, мочевины, мочевой кислоты, креатина, креатинина 14-28
ммоль/л;
в) углеводы в виде глюкозы 3,6-6,5 ммоль/л;
г) липиды, в зависимости от характера принятой пищи – 2,0-4,0 г/л.
2. Неорганическими соединениями.
Общее количество неорганических веществ плазмы крови составляет
около 0,9%. К ним относятся:
1) катионы (Na+, K+, Ca+, Mg+);
2) анионы (Cl-, SO42-, PO42-, HCO3-;
3) микроэлементы (йод, бром, железо, медь, марганец, цинк и др.).
Содержание некоторых веществ в плазме крови колеблется в очень небольших пределах. Такие
показатели называются жесткими константами, поскольку при существенных сдвигах их
концентрации существует опасность нарушения функции клеток, приводящая к гибели
организма.
8.
Слайд 7Функции белков крови.
1. Питательная функция.
2. Транспортная функция.
3. Создание онкотического давления.
4. Буферная функция – За счет наличия в составе белков плазмы щелочных и кислых
аминокислот, белки участвуют в поддержании кислотноосновного равновесия.
5. Участие в процессах гемостаза. Процесс свертывания включает целую
цепь реакций, в которых участвует ряд белков плазмы (фибриноген и др.).
6. Белки вместе с эритроцитами определяют вязкость крови – 4,0-5,0, что в свою очередь
оказывает влияние на гидростатическое давление крови, СОЭ и др.
Вязкость плазмы составляет 1,8 – 2,2 (1,8-2,5). При обильном белковом питании вязкость
плазмы и крови повышается.
7. Белки являются важным компонентом защитной функции крови (особенно γ-глобулины).
Они обеспечивают гуморальный иммунитет, являясь антителами.
Все белки плазмы крови делят на 3 группы:
альбумины,
глобулины,
фибриноген.
9.
Слайд 8К форменным элементам крови относятся:
эритроциты,
лейкоциты,
тромбоциты.
Гемограмма взрослого человека в норме (средние показатели):
эритроциты – 4,0-5,5 х 1012/л,
лейкоциты – 4,0-8,0 х 109/л,
тромбоциты – 200-400 х 109/л.
Все клетки крови развиваются из общей полипотентной стволовой клетки крови в эмбриогенезе
(эмбриональный гемопоэз) и после рождения (постэмбриональный гемопоэз)
10.
Слайд 911.
Слайд 1012.
Слайд 1113.
Слайд 1214.
Слайд 13Эритроциты
– самые многочисленные клетки крови, утратившие в процессе
дифференцировки ядро и практически все органеллы. Большинство эритроцитов (75-85 %)
имеют форму двояковогнутого диска для обеспечения большей площади поверхности,
способности к обратимой деформации при прохождении через капилляры. При нарушении
осмотического равновесия или целостности цитоскелета изменяется форма эритроцита, что
может свидетельствовать о старении клетки или патологии.
15.
Слайд 14Свойства эритроцитов.
1. Пластичность (деформируемость) – это способность эритроцитов к обратимой деформации
при прохождении через микропоры и узкие извитые капилляры диаметром до 2,5-3 мкм. Это
свойство обеспечивается благодаря особой форме эритроцита – двояковогнутого диска.
2. Осмотическая стойкость эритроцитов. Осмотическое давление в эритроцитах несколько
выше, чем в плазме, что обеспечивает тургор клеток. Оно создается более высокой
внутриклеточной концентрацией белков по сравнению с плазмой крови.
3. Агрегация эритроцитов. При замедлении движения крови и повышении ее вязкости
эритроциты образуют агрегаты или монетные столбики. Вначале агрегация носит обратимый
характер, но при более длительном нарушении кровотока образуются истинные агрегаты, что
может привести к микротромбообразованию.
4. Эритроциты способны отталкиваться друг от друга, что связано со строением
мембраны эритроцитов. Гликопротеины, составляющие 52% массы мембраны, содержат
сиаловую кислоту, которая придает отрицательный заряд эритроцитам.
16.
Слайд 15Эритроцит функционирует максимум 120 дней, в среднем 60-90 дней. По мере старения
способность эритроцитов к деформации снижается, а превращение их в сфероциты (имеющие
форму шара) за счет изменения цитоскелета приводит к тому, что они не могут проходить через
капилляры диаметром до 3 мкм.
Эритроциты разрушаются внутри сосудов (внутрисосудистый гемолиз) или захватываются и
разрушаются макрофагами в селезенке, купферовских клетках печени и костном мозге
(внутриклеточный гемолиз).
Ключевая задача эритроцитов напрямую связана с входящим в их состав гемоглобином.
17.
Слайд 16Гемоглобин
Основные свойства эритроцитов связаны в наличии в нем белка гемоглобина. Этот белок
обладает способностью связываться с кислородом и углекислым газом, осуществляя
транспортировку первого к тканям и органам, а второго — обратно к легким.
Каждый эритроцит содержит 270–400 млн молекул гемоглобина.
18.
Слайд 17Модель молекулы гемоглобина
Гемоглобин (Hb) — сложный железосодержащий белок, содержащийся в эритроцитах
(красных кровяных тельцах) крови и частично присутствующий в свободном виде в плазме.
Именно он осуществляет перенос кислорода от легких к клеткам и углекислого газа — в
обратном направлении.
Благодаря своим уникальным химическим свойствам гемоглобин является ключевым элементом
буферной системы крови, поддерживающим кислотно-щелочной баланс в организме. Hb
связывает и выводит на клеточном уровне кислые соединения (препятствует ацидозу —
закислению тканей и крови). А в легких, куда он поступает в форме карбгемоглобина (HbCO2), за
счет синтеза углекислоты предотвращает противоположный процесс — защелачивание крови,
или алкалоз.
Количество гемоглобина
зависит от возраста и пола,
меняется в процессе
вынашивания и рождения
ребенка.
19.
Слайд 18Уровень гемоглобина в нашей крови может несколько увеличиваться и уменьшаться по
естественным причинам. Обновление гемоглобина связано с жизненным циклом эритроцита, к
которому он прикреплен. Так, примерно каждые 120 дней часть молекул гемоглобина вместе с
эритроцитами отправляется в печень — на расщепление и после вновь синтезируется,
присоединяясь к свободному эритроциту.
На гемоглобин также оказывают влияние специфические условия труда или проживания
(например, повышенные показатели бывают у пилотов и жителей гористой местности),
приверженность вегетарианству и донорство (эти факторы, напротив, снижают гемоглобин)
Согласно рекомендациям, нормой гемоглобина считается:
для детей от полугода до 5 лет — 110 г/л и выше;
для детей 5–11 лет — 115 г/л и больше;
для детей 12–14 лет, а также девушек и женщин (15 лет и старше) — 120 г/л и выше;
для мужчин (15 лет и старше) — 130–160 г/л.
Функции гемоглобина заключаются в обеспечении дыхательного процесса в организме, который
осуществляется в три этапа:
1. клеточное дыхание – клетки насыщаются кислородом;
2. внешнее дыхание – в легкие поступает кислород, а организмом выделяется углекислый газ;
3. внутреннее дыхание – в легких кислород захватывает гемоглобин, они трансформируются в
оксигемоглобин и разносятся по всем клеткам.
Именно поэтому нарушение баланса данного белка может приводить к крайне негативным
последствиям, а в отдельных случаях даже к летальному исходу.
Оценивая их концентрацию, насыщенность и даже форму, врач может получить важные данные
для постановки правильного диагноза или оценки эффективности лечения.
20.
Слайд 19Содержание эритроцитов в крови у мужчин и женщин отличается. Также эти показатели зависят
от возраста.
Норма концентрации эритроцитов в крови:
- Для новорожденных характерны показатели в 3,9–5,9 млн/мкл.
-У детей от 1 до 12 лет нормой эритроцитов в крови является 3,8–5 млн/мкл.
С возрастом в силу вступают половые различия —–
- для юношей 12–18 лет нормальные показатели эритроцитов должны находиться в границах от
4,1 до 5,6 млн/мкл,
-а у девушек —– от 3,8 до 5,1. млн/мкл,
В крови взрослых мужчин обычно содержится 4,3–5,8 миллионов клеток на микролитр,
женщин —– 3,8–5,2.
Организм беременных женщин имеет свои особенности, в этот период он активно накапливает
жидкость, а значит и состав крови подвергается существенным трансформациям. Поэтому для
будущих мам нормальным явлением будет небольшое снижение уровня красных кровяных
телец.
Изменение количества эритроцитов в крови человека может означать как
наличие заболевания, так и определенные состояния организма.
21.
Слайд 20 Что означает повышенный уровень эритроцитов в кровиВысокий уровень красных кровяных телец врачи называют эритроцитозом. Часто поводом для
увеличения числа эритроцитов в крови человека становится обезвоживание, возникшее
вследствие естественных причин, а также при диарее, рвоте, высокой температуре. Поэтому
анализ крови не рекомендуется проходить после тяжелых физических нагрузок. Кроме того
повышенный уровень эритроцитов в крови может быть характерен при авитаминозе, а также для
жителей высокогорных областей и людей и чья профессия связана с авиаперелетами.
К патологическим причинам повышенного уровня эритроцитов относятся такие заболевания, как
недостаточность сердечно-сосудистой или дыхательной системы, а также поликистоз почек и
эритремия.
По аналогии с повышенным уровнем эритроцитов, снижение количества этих клеток может быть
вызвано гипергидратацией, то есть чрезмерной насыщенностью тканей жидкостью.
Наличие раковых опухолей с метастазами, хронические воспаления, а также любая из
разновидностей анемии также способны стать причиной низкого уровня эритроцитов в крови
пациента.
Реже дело в различных сбоях иммунной системы, когда организм человека начинает
вырабатывать антитела к эритроцитам, самостоятельно уничтожая их.
Нарушения работы красного костного мозга, где и образуются «молодые» клетки, иногда
становится причиной снижения уровня ретикулоцитов в крови.
Кроме того такое явление может быть вызвано апластической и гипопластической анемиями.
22.
Слайд 21Патологии формы эритроцитов
Некоторые виды анемии (например, гемолитическая) могут спровоцировать преобладание
эритроцитов уменьшенного размера (диаметр одной клетки составляет меньше 6,5 мкм) —
такое явление называется микроцитозом.
Небольшие размеры эритроцитов могут стать причиной накопления воды в клетке, в результате
чего форма ее изменяется, все более приближаясь к округлой.
23.
Слайд 2224.
Слайд 23Патологические формы эритроцитов
25.
Слайд 24Лейкоциты
Лейкоциты или белые кровяные тельца – это клетки крови, различной формы и величины,
содержащие ядра.
В среднем у взрослого здорового человека в крови содержится 4 – 9 х 109/л лейкоцитов.
26.
Слайд 25Функции лейкоцитов:
1. Защитная (участие в обеспечении неспецифической резистентности и создании гуморально-го и
клеточного иммунитета).
2. Метаболическая (выход в просвет пищеварительного тракта, захват там питательных веществ и
перенос их в кровь. Особенно это имеет существенное значение в поддержании иммунитета у
новорожденных в период молочного вскармливания за счет переноса в кровь в неизмененном
виде иммуноглобулинов из материнского молока).
3. Гистолитическая - лизис (растворение) поврежденных тканей;
4. Морфогенетическая - уничтожение различных закладок в период эмбрионального развития.
27.
Слайд 2628.
Слайд 27Лейкоциты. Общая характеристика и
классификация
Лейкоциты (leucocytus), или белые кровяные клетки, в свежей крови бесцветны, что отличает их
от окрашенных эритроцитов. Их число в 1000 раз меньше, чем эритроцитов.
Лейкоциты в кровяном русле и лимфе способны к активным движениям, могут проходить через
стенку сосудов в соединительную ткань органов, где они выполняют основные защитные
функции.
Лейкоциты отличаются друг от друга по строению и функциям. Главным признаком,
отличающим лейкоциты (по строению), является наличие или отсутствие в них специфических
гранул, воспринимающих окраску. По этому принципу их разделяют на гранулоциты и
агранулоциты.
Гранулоциты, воспринимающие щелочную окраску, называются базофилами. Те, которые
прокрашиваются кислотами – эозинофилами. Гранулоциты, окрашивающиеся двумя
разновидностями красителей, называются нейтрофилы.
Агранулоциты подразделяются на моноциты и лифмоциты, которые в свою очередь
подразделяются на Т и B-лимфоциты.
29.
Слайд 28Формы лейкоцитов
У зернистых лейкоцитов при окраске крови по Романовскому-Гимзе смесью кислого (эозин) и
основного (азур II) красителей в цитоплазме выявляются специфическая зернистость
(эозинофильная, базофильная или нейтрофильная) и сегментированные ядра.
В соответствии с окраской специфической зернистости различают нейтрофильные,
эозинофильные и базофильные гранулоциты.
Группа незернистых лейкоцитов - лимфоциты и моноциты - характеризуется отсутствием
специфической зернистости и несегментированными ядрами.
Процентное соотношение основных видов лейкоцитов называется лейкоцитарной формулой.
Общее число лейкоцитов и их процентное соотношение у человека могут изменяться в норме в
зависимости от употребляемой пищи, физического и умственного напряжения и при различных
заболеваниях. Именно поэтому исследование показателей крови необходимо для установления
диагноза и назначения лечения.
30.
Слайд 29Все лейкоциты способны к активному перемещению путем образования псевдоподий, при этом
у них изменяется форма тела и ядра.
Они способны проходить между клетками эндотелия сосудов и клетками эпителия, через
базальные мембраны и перемещаться по основному веществу (матриксу) соединительной ткани.
Скорость движения лейкоцитов зависит от следующих условий: температуры, химического
состава, рН, консистенции среды и др.
Направление движения лейкоцитов определяется хемотаксисом под влиянием химических
раздражителей - продуктов распада тканей, бактерий и др.
Лейкоциты выполняют защитные функции, обеспечивая фагоцитоз микробов (гранулоциты,
макрофаги), инородных веществ, продуктов распада клеток (моноциты - макрофаги), участвуя в
иммунных реакциях (лимфоциты, макрофаги).
Лейкоциты или белые кровяные клетки, в отличии от эритроцитов, имеют ядро и другие
структурные элементы, свойственные клеткам.
Их размер от 7,5 до 20 мкм.
Они содержат целый ряд ферментов (протеазы, пептидазы, диастазы, липазы и др.). Ферменты в
обычных условиях находятся в изолированном состоянии в лизосомах (лизосомные ферменты).
Для лейкоцитов характерно амебовидное движение. Они способны выходить из кровеносного
русла (скорость их движения 40 мкм/мин). Выход лейкоцитов через эндотелий капилляров
называется диапедезом. После выхода из сосуда они направляются к месту внедрения
инородного фактора, очагу воспаления, продуктам распада тканей (положительный
хемотаксис). Отрицательный хемотаксис - это направление движения лейкоцитов от места
внедрения патогенного фактора.
31.
Слайд 30Гранулоциты (зернистые лейкоциты)
К гранулоцитам относятся:
-нейтрофильные,
- эозинофильные,
-базофильные лейкоциты.
Они образуются в красном костном мозге, содержат специфическую зернистость в цитоплазме и
имеют сегментированные ядра.
32.
Слайд 31Ультрамикроскопическое строение
гранулоцитов
а - сегментоядерный нейтрофильный гранулоцит;
б - эозинофильный (ацидофильный) гранулоцит;
в - базофильный гранулоцит.
1 - сегменты ядра;
2 - тельце полового хроматина;
3 - первичные (азурофильные) гранулы
4 - вторичные (специфические) гранулы;
5 - зрелые специфические гранулы эозинофила,
содержащие кристаллоиды;
6 - гранулы базофила различной величины и
плотности;
7 - периферическая зона цитоплазмы,
не содержащая органелл;
8 - микроворсинки и псевдоподии
33.
Слайд 32Нейтрофильные гранулоциты
Нейтрофильные гранулоциты (нейтрофильные лейкоциты, или нейтрофилы) - самая
многочисленная группа лейкоцитов, составляющая 2,0- 5,5 х 109/л крови (48-78 % общего числа
лейкоцитов). Их диаметр в мазке крови 10-12 мкм, а в капле свежей крови 7-9 мкм.
В зрелом сегментоядерном нейтрофиле ядро имеет 3-5 сегментов, соединенных тонкими
перемычками.
34.
Слайд 33Тельце Барра
В ядре нейтрофилов гетерохроматин занимает широкую зону по периферии ядра, а эухроматин
расположен в центре. Для женщин характерно наличие в ряде нейтрофилов полового
хроматина (Х-хромосома) в виде барабанной палочки - тельце Барра (corpusculum chromatini
sexualis), которое имеет форму висячей капли и соединено с ядром тонкой перемычкой.
35.
Слайд 34 Цитоплазма нейтрофилов при окраске поРомановскому-Гимзе
Цитоплазма нейтрофилов при окраске по Романовскому-Гимзе окрашивается слабооксифильно,
в ней видна очень мелкая зернистость розово-фиолетового цвета (окрашивается кислыми и
основными красками), поэтому называется нейтрофильной, или гетерофильной. В поверхностном слое цитоплазмы зернистость и органеллы отсутствуют. Здесь расположены гранулы
гликогена, актиновые филаменты и микротрубочки, обеспечивающие образование псевдоподий
для движения клетки. Сокращение актиновых филаментов обеспечивает передвижение клетки
по соединительной ткани.
36.
Слайд 35Строение клетки нейтрофилов
Во внутренней части цитоплазмы расположены органеллы (комплекс Гольджи, гранулярная
эндоплазматическая сеть, единичные митохондрии), видна зернистость.
Число зерен в каждом нейтрофиле варьирует и составляет 50-200.
В нейтрофилах можно различить два типа гранул: специфические и азурофильные, окруженные
одинарной мембраной.
Специфические гранулы, более светлые, мелкие и многочисленные, составляют 80-90 % всех
гранул. Их размер около 0,2 мкм, они электронно-прозрачны, но могут содержать кристаллоид. В
них обнаружены щелочная фосфатаза, бактерицидные ферменты (лизоцим, лактоферрин), белок,
связывающий витамин В12, коллагеназа.
Азурофильные гранулы (лизосомо-подобные) более крупные (~0,4 мкм), окрашиваются в
фиолетово-красный цвет, имеют электронно-плотную сердцевину; их количество составляет 10-20 %
всей популяции гранул. В них содержатся миелопероксидаза, набор разнообразных
гидролитических ферментов, катионные белки, лизоцим, гликозаминогликаны.
Азурофильные гранулы в процессе дифференцировки нейтрофилов в костном мозге появляются
раньше, поэтому называются первичными в отличие от вторичных - специфических.
37.
Слайд 36Показатель нейтрофилов в крови
Показатель нейтрофилов в крови напрямую зависит от возраста человека.
У детей до одного года нейтрофилы составляют от 30 % до 50 % от лейкоцитов, когда ребенок
растет, у него начинает увеличиваться уровень нейтрофилов, в семь лет количество должно
быть от 35% до 55%.
У взрослых норма может колебаться от 45% до 70%.
В случаи отклонения от нормы, когда показатель ниже, можно говорить о пониженном уровне
нейтрофилов.
Состояние, когда в крови нейтрофилы понижены, называется в медицине нейтропенией.
Обычно это говорит о быстром разрушении этих клеток, органическим или функциональным
нарушением кроветворения в костном мозге, истощением организма после длительно
протекающих заболеваний.
О нейтропении говорят, если содержание нейтрофилов у взрослого человека ниже нормы и
составляет от 1,6Х10⁹ и меньше. Снижение может быть истинным, если изменяется их
количество в крови, и относительным, если уменьшается их процент по отношению к
остальным лейкоцитом.
38.
Слайд 37В популяции нейтрофилов крови могут находиться клетки различной степени зрелости:
-юные,
-палочкоядерные,
-сегментоядерные.
Первые два вида - молодые клетки. Доля юных клеток в норме не превышает 0,5 % или они
вообще отсутствуют. Эти клетки характеризуются бобовидным ядром.
Палочкоядерные составляют 1-6 %, имеют несегментированное ядро в форме буквы S,
изогнутой палочки или подковы.
Увеличение содержания в крови юных и палочкоядерных нейтрофилов свидетельствует о
наличии кровопотери или воспалительного
процесса, сопровождающихся усилением
гемопоэза в костном мозге и выходом
молодых форм.
39.
Слайд 3840.
Слайд 3941.
Слайд 4042.
Слайд 4143.
Слайд 42Сегментоядерные нейтрофильные гранулоциты
Сегментоядерные нейтрофильные гранулоциты имеют размер 10–15 мкм, полиморфное узкое
ядро разделено на 3–5 отдельных сегментов, соединенных тонкими, не всегда заметными
перемычками. Базихроматин ядра скапливается в отдельные грубые комочки, преимущественно
по периферии ядра, окрашивая его в темно-фиолетовый цвет. Структура ядра неравномерная,
крупноглыбчатая. Цитоплазма розоватого цвета, содержит обильную мелкую бледнофиолетовую зернистость. Ядерно-цитоплазматическое отношение сдвинуто в пользу
цитоплазмы. Полисегментированные нейтрофилы (6–12 сегментов и более) встречаются при
патологии — В12-дефицитной анемии, хроническом миелофиброзе, МДС, лучевой болезни.
44.
Слайд 43Палочкоядерный нейтрофильный лейкоцит
Палочкоядерные нейтрофильные гранулоциты — это клетки размером 9–12 (10–15) мкм,
имеющие темно-фиолетовое ядро, узкое, вытянутое в виде палочки средней толщины, часто
изогнутой. Структура ядра грубая, неравномерная, крупно-глыбчатая, без нуклеол. Цитоплазма
розоватого цвета, иногда с фиолетовым оттенком занимает большую часть клетки, содержит
обильную неравномерную мелкую розовато-синюю или бледно-фиолетовую зернистость.
45.
Слайд 44Зернистость нейтрофильного лейкоцита
Нейтрофильная зернистость розовато-фиолетовой окраски, чаще пылевидная, обильная, не
всегда равномерно заполняет цитоплазму.
46.
Слайд 45Основная функция нейтрофилов
Основная функция нейтрофилов - фагоцитоз микроорганизмов, поэтому их называют
макрофагами. В процессе фагоцитоза бактерий сначала (в течение 0,5-1 мин) с
образующейся фагосомой (захваченная бактерия) сливаются специфические гранулы,
ферменты которой убивают бактерию, при этом образуется комплекс, состоящий из
фагосомы и специфической гранулы. Позднее с этим комплексом сливается лизосома,
гидролитические ферменты которой переваривают микроорганизмы. При распаде
нейтрофилов и бактериальных токсинов выделяются вещества, которые названы
пирогенами. Последние с током крови попадают к центрам регуляции температуры
тела, вызывают ее повышение. Кроме того, они стимулируют образование нейтрофилов
в костном мозге.
47.
Слайд 46Базофильные гранулоциты
Базофильные гранулоциты (базофилы) – их количество в крови составляет 0-0,06×109/л, или
0-1 % общего числа лейкоцитов. Их диаметр в мазке крови составляет 11-12 мкм, в капле свежей
крови - около 9 мкм.
В цитоплазме выявляются все виды органелл - эндоплазматическая сеть, рибосомы, комплекс
Гольджи, митохондрии, актиновые филаменты. Характерно наличие специфических крупных
метахроматических гранул числом около 400, часто закрывающих ядро, размеры которых
варьируют от 0,5 до 1,2 мкм. Метахромазия (азур II окрашивает гранулы в фиолетовый цвет)
обусловлена наличием гепарина – гликозаминогликана.
Базофильные гранулоциты имеют
несколько меньший размер
— 8–12 мкм.
48.
Слайд 47Базофильные сегментоядерные гранулоциты
Базофильные сегментоядерные гранулоциты имеют трехсегментированное, сравнительно
крупное фиолетовое ядро, иногда неопределенной формы или в виде листа растения. Структура
ядра неравномерная, крупноглыбчатая. Цитоплазма фиолетовая или бледно-розовая, нередко с
размытыми участками (часть зерен растворяется в воде), содержит необильную, неравномерную
зернистость грязноватого темно-фиолетового цвета, расположенную на ядре и в цитоплазме.
Сегментоядерные базофилы отличить от палочкоядерных форм в большинстве случаев
невозможно из-за обильной зернистости, покрывающей ядро.
49.
Слайд 48Специфические гранулы содержат пероксидазу, гистамин, гепарин, АТФ, факторы хемотаксиса
нейтрофилов и эозинофилов и др. Часть гранул представляют собой модифицированные
лизосомы. При электронно-микроскопическом исследовании видны окружающая гранулы
мембрана и кристаллическая область. Гранулы неоднородны по электронной плотности.
50.
Слайд 49Помимо специфических гранул, в базофилах содержатся и азурофильные гранулы (лизосомы).
Базофилы, как и тучные клетки соединительной ткани, выделяя гепарин и гистамин, участвуют в
регуляции процессов свертывания крови и проницаемости стенки сосудов. Базофилы участвуют
в иммунологических реакциях организма. Дегрануляция базофилов происходит при реакциях
гиперчувствительности немедленного типа (например, при астме, анафилаксии, сыпи, которая
может ассоциироваться с покраснением кожи).
Базофилы образуются в костном мозге. Они циркулируют в крови до 1 сут, затем мигрируют в
ткани, где в течение 1-2 сут выполняют свои функции и затем погибают.
51.
Слайд 50Зернистость эозинофильных лейкоцитов
Зрелые эозинофилы человека имеют ядро, разделённое на две части (двудольное), и
эозинофильные гранулы, содержащие белки с цитотоксическими свойствами. У здорового
человека эозинофилы составляют от 0,5 % до 5 % от общего числа лейкоцитов.
Эозинофильная зернистость однородна по цвету, форме и величине, крупная, занимает всю
цитоплазму. В зрелых клетках эозинофильного ряда она имеет кирпично-розовый цвет
(кетовая икра), в молодых — коричневый и буро-синий оттенок.
В крови эозинофилы циркулируют от 30 минут до 18 часов, после чего перемещаются в ткани
и пребывают там 10—12 суток.
Многие белки, входящие в состав гранул эозинофилов, обладают
токсичностью в отношении гельминтов:
52.
Слайд 51Эозинофильный лейкоцит
Эозинофильные гранулоциты — клетки размером 12–15 мкм, имеют более крупное ядро, чем у
нейтрофилов, и меньшее число сегментов (2, реже 3). Ядро рыхлое, окрашивается бледнее, чем
у нейтрофильных гранулоцитов, а цитоплазма бледно-розовая (бледно-голубая у
эозинофильных палочкоядерных гранулоцитов). Зернистость обильная, крупная, розовая,
занимает всю цитоплазму. Палочкоядерные эозинофильные гранулоциты встречаются редко.
В цитоплазме расположены органеллы - комплекс Гольджи (около ядра), немногочисленные
митохондрии, актиновые фила-менты в цитоплазме под плазмолеммой и гранулы числом до
200. Среди гранул различают азурофильные (первичные) и эозинофильные (вторичные),
являющиеся модифицированными лизосомами. Они электронно-плотные, содержат
гидролитические ферменты.
Специфические эозинофильные
гранулы заполняют почти всю
цитоплазму, имеют размер 0,6-1 мкм.
Характерно наличие в центре гранулы
кристаллоида, который содержит
главный основной белок, богатый
аргинином (что обусловливает
оксифилию гранул), лизосомные
гидролитические ферменты,
пероксидазу и другие
белки - эозинофильный катионный белок, гистаминазу.
53.
Слайд 52Эозинофильные (ацидофильные)
гранулоциты
Эозинофильные (ацидофильные) гранулоциты (эозинофилы). Количество эозинофилов в крови
составляет 0,02- 0,3*109/л, или 0,5-5 % общего числа лейкоцитов. Их диаметр в мазке крови
равен 12-14 мкм, в капле свежей крови - 9-10. Ядро эозинофилов имеет, как правило, 2 сегмента,
соединенных перемычкой.
54.
Слайд 5355.
Слайд 54Специфической функцией эозинофилов является антипаразитарная. При паразитарных
заболеваниях (гельминтозы, шистосомоз и др.) наблюдается значительное увеличение числа
эозинофилов - до 90 % общего числа лейкоцитов. Эозинофилы убивают личинки паразитов,
поступившие в кровь или органы (например, в слизистую оболочку кишки).
Они привлекаются в очаги воспаления хемотаксическими факторами и прилипают к паразитам
благодаря наличию на них обволакивающих компонентов комплемента крови. При этом
происходят дегрануляция эозинофилов и выделение белка, разрушающего кутикулу паразитов.
Эозинофилы находятся в периферической крови менее 12 ч и потом переходят в ткани.
Их мишенями являются такие органы, как кожа, легкие и пищеварительный тракт, где они
выполняют свои функции в течение 8-12 сут.
Изменение содержания эозинофилов может наблюдаться под действием медиаторов и гормонов:
например, при стресс-реакции отмечается снижение числа эозинофилов в крови, обусловленное
увеличением содержания гормонов надпочечников.
56.
Слайд 5557.
Слайд 5658.
Слайд 57Агранулоциты
(незернистые лейкоциты)
Агранулоциты (незернистые лейкоциты)
К этой группе лейкоцитов относятся лимфоциты и моноциты. В отличие от гранулоцитов они.
не содержат в цитоплазме специфической зернистости, а их ядра не сегментированы.к
агранулоцитам
Лимфоциты (lymphocytus). В крови взрослых людей они составляют 20-35 % общего числа
лейкоцитов (1,0-4,0×109/л). Величина лимфоцитов в мазке крови значительно варьирует - от
4,5 до 10 мкм. Среди них различают малые лимфоциты (диаметром 4,5-6 мкм), средние
(диаметром 7-10 мкм) и большие (диаметром 10 мкм и более).
Большие лимфоциты встречаются в крови новорожденных и детей, у взрослых они
отсутствуют.
59.
Слайд 5860.
Слайд 5961.
Слайд 60Для всех видов лимфоцитов характерно наличие интенсивно окрашенного ядра округлой или
бобовидной формы, содержащего компактный гетеро-хроматин, и относительно узкого ободка
базофильной цитоплазмы. В цитоплазме некоторых лимфоцитов содержится небольшое
количество азуро-фильных гранул (лизосомы). Малые лимфоциты составляют большую часть
(85-90 %) всех лимфоцитов крови человека.
62.
Слайд 61 Ультрамикроскопическое строение лимфоцитаПри электронной микроскопии в их ядрах выявляются небольшие впячивания; гетерохроматин
расположен преимущественно по периферии ядра. В цитоплазме обнаруживаются пузырьки,
лизосомы, свободные рибосомы, полисомы, митохондрии, комплекс Гольджи, центриоли,
небольшое количество элементов гранулярной эндоплазматической сети.
1- ядро;
2 - рибосомы;
3-микроворсинки;
4 - центриоль;
5- комплекс Гольджи;
6 - митохондрии
63.
Слайд 62Морфология лимфоцитов
По морфологическим признакам выделяют два типа лимфоцитов:
большие гранулярные лимфоциты (чаще всего ими являются NK-клетки или,
значительно реже, это активно делящиеся клетки лимфоидного ряда — лимфобласты
и иммунобласты) и
малые лимфоциты (T- и B-клетки).
Среди малых лимфоцитов различают светлые и темные. Малые темные лимфоциты
меньше светлых, имеют более плотное ядро, более узкий ободок базофильной
цитоплазмы, обладающей высокой электронной плотностью. В цитоплазме
расположено большое количество рибосом.
Основной функцией лимфоцитов является участие в иммунных реакциях. Однако
популяция лимфоцитов разнообразна по характеристике поверхностных рецепторов и
роли в реакциях иммунитета.
.
64.
Слайд 63 Большие лимфоциты. Малые лимфоциты.Большие лимфоциты (12 % от общего числа лимфоцитов) характеризуются присутствием в
цитоплазме свободных рибосом, митохондрий и длинных канальцев эндоплазматической сети.
В этих клетках ядро крупное, широкая зона цитоплазмы, хроматин менее плотный, чем у малых
лимфоцитов, распределяется равномерно, почти всегда обнаруживается ядрышко.
Малые светлые лимфоциты составляют 15 % всех лимфоцитов периферической крови и
отличаются от других групп клеток бедной органеллами цитоплазмой. Из-за незначительного
количества рибосом их цитоплазма выглядит светлой. Ядро занимает практически всю клетку,
приближается к сферической форме. Иногда в ядрах обнаруживается довольно глубокая борозда
или вырез. Хроматин, как правило, имеет вид грубых, компактных глыбок. Значительный объем
ядра по отношению к цитоплазме составляет существенный морфологический признак
лимфоцита. Ни одна другая клетка в организме не имеет меньше цитоплазмы, чем лимфоцит.
Малые темные лимфоциты (12%) содержат большое число рибосом в цитоплазме, что
обусловливает
их
темное
окрашивание
в
световом
микроскопе,
гранулярная
эндоплазматическая сеть развита слабо.
65.
Слайд 64Средние лимфоциты
Средние лимфоциты составляют около 10-12 % лимфоцитов крови человека. Ядра этих клеток
округлые, иногда бобовидные с пальцевидным впячиванием ядерной оболочки. Хроматин более
рыхлый, ядрышко хорошо выражено. В цитоплазме расположены удлиненные канальцы
гранулярной эндоплазматической сети, элементы агранулярной сети, свободные рибосомы и
полисомы, лизосо-мы. Центросома и комплекс Гольджи расположены рядом с областью
инвагинации ядерной оболочки.
Кроме типичных лимфоцитов, в крови человека в небольшом количестве могут встречаться
лимфоплазмоциты (около 1-2 %), которые отличаются концентрическим расположением вокруг
ядра канальцев гранулярной эндоплазматической сети.
Основной функцией лимфоцитов является участие в иммунных реакциях. Однако популяция
лимфоцитов разнообразна по характеристике поверхностных рецепторов и роли в реакциях
иммунитета.
.
66.
Слайд 65Классификация лимфоцитов
67.
Слайд 66В-лимфоциты, Т-лимфоциты
Среди лимфоцитов различают три основных функциональных класса:
-В-лимфоциты,
-Т-лимфоциты,
-нулевые лимфоциты
68.
Слайд 6769.
Слайд 6870.
Слайд 69В- лимфоциты. Т-лимфоциты.
Среди лимфоцитов различают три основных функциональных класса: В-лимфоциты, Тлимфоциты и нулевые лимфоциты.
В-лимфоциты впервые были обнаружены в фабрициевой сумке птиц (bursa Fabricius),
поэтому и получили соответствующее название. Они образуются у эмбриона человека из
стволовых клеток - в печени и костном мозге, а у взрослого - в костном мозге.
В-лимфоциты составляют около 30 % циркулирующих лимфоцитов. Их главная функция участие в выработке антител, т. е. обеспечение гуморального иммунитета. Плазмолемма Влимфоцитов содержит множество рецепторов иммуноглобулина. При действии антигенов Влимфоциты способны к пролиферации и дифференцировке в плазмоциты - клетки, способные
синтезировать и секретировать защитные белки - иммуноглобулины (Ig), которые поступают в
кровь, обеспечивая гуморальный иммунитет.
Т-лимфоциты, или тимусзависимые лимфоциты, образуются из стволовых клеток костного
мозга, а созревают в тимусе, что и обусловило их название. Они преобладают в популяции
лимфоцитов, составляя около 70 % циркулирующих лимфоцитов. Для Т-клеток, в отличие от
В-лимфоцитов, характерен низкий уровень рецепторов иммуноглобулина в плазмолемме.
Однако Т-клетки имеют специфические рецепторы, способные распознавать и связывать
антигены, участвовать в иммунных реакциях. Основными функциями Т-лимфоцитов являются
обеспечение реакций клеточного иммунитета и регуляция гуморального иммунитета
(стимуляция или подавление дифференцировки В-лимфоцитов).
Т-лимфоциты способны к выработке лимфокинов, которые регулируют деятельность Влимфоцитов и других клеток в иммунных реакциях.
71.
Слайд 7072.
Слайд 71Среди Т-лимфоцитов выявлено несколько функциональных групп: Т-хелперы, Т-супрессоры, Ткиллеры.
73.
Слайд 7274.
Слайд 73В-лимфоциты
В-лимфоциты вырабатывают своеобразные защитные вещества, так называемые антитела. С
помощью антител обезвреживаются попадающие в организм чужеродные белки, которые
обладают ядовитыми свойствами. Если человек переболел некоторыми инфекционными
заболеваниями, то в дальнейшем он становится невосприимчивым к ним. Это объясняется
тем, что в организме образовались антитела, которые защищают его от повторного
заболевания.
75.
Слайд 7476.
Слайд 7577.
Слайд 76Отличие гранулоцитов от агранулоцитов
Агранулоциты - это одноядерные лейкоциты, один из двух типов лейкоцитов. Агранулоциты
содержат ядро овальной формы и незернистуюц итоплазму. Существуют два основных типа
агранулоцитов:
Моноциты и
лимфоциты.
У лимфоцитов может наблюдаться токсогенная зернистость. Моноциты и Мкф также имеют
пыливидную зернистость.
Гранулоциты- это одноядерные лейкоциты, (в отличии от агранулоцитов). В отличие от
агранулоцитов, гранулоциты - это зернистые (полиморфноядерные)лейкоциты. Они содержат
разделенное на различное количество связанных сегментов ядро и зернистую цитоплазму.
Гранулоциты обладают способностью к амебоидному движению. Гранулоциты подразделяют
нанейтрофилы, эозинофилы и базофилы.
Агранулоциты по пути из ККМ в ткани циркулируют дольше, чем агранулоциты.
Гранулоциты не способны рециркулировать обратно в кровь, а агранулоциты способны,
причем по несколько раз.
Для эозинофилов вопрос о рециркуляции открыт! (Возможно гиперэозинофилия результат
рециркуляции.)
Только агранулоциты способны к пролиферации и дифференциации в месте своего
функционирования. Гранулоциты не превращаются и не делятся
Отличие в CD- маркерах на поверхности клетки.
Гранулоцитопоэз происходит в ККМ (все стадии), агранулоцитопоэз- завершается в крови и
тканях.
Ядерноцитоплазмотический индекс (ЯЦИ) у гранулоцитов меньше 1, цитоплазма занимает
78.
Слайд 77Время жизни лимфоцитов
В настоящее время оценка иммунного статуса организма в клинике проводится с помощью
иммунологических и иммуноморфологических методов выявления различных видов
лимфоцитов.
Продолжительность жизни лимфоцитов варьирует от нескольких недель до нескольких лет.
Т-лимфоциты являются «долгоживущими» (месяцы и годы) клетками, а В-лимфоциты
относятся к «короткоживущим» (недели и месяцы).
Для Т-лимфоцитов характерно явление рециркуляции, т. е. выход из крови в ткани и
возвращение по лимфатическим путям снова в кровь. Таким образом, они осуществляют
иммунологический надзор за состоянием всех органов, быстро реагируя на внедрение
чужеродных агентов.
79.
Слайд 78Моноциты
Моноциты — самые крупные клетки, размером 12–20 мкм. Ядро занимает большую или
равную с цитоплазмой часть клетки. Оно светло-фиолетового цвета, иногда голубоватое или
красно-фиолетовое, полиморфной формы — округлое, бобовидное, трехлопастное, в виде
бабочки, с нежной, равномерной, крупносетчатой структурой (как бы разрежено). Нити
базихроматина в виде извилистых грубых тяжей образуют широкую сетку с утолщениями. В
ячейках сетки имеются значительные просветления за счет оксихроматина. Цитоплазма
бледно-голубая или сероватая (дымчатая), иногда синяя, часто содержит большое количество
мелкой, пылевидной, азурофильной зернистости. Нередко в цитоплазме содержатся вакуоли,
расположенные вокруг ядра, фагоцитированные клетки, пигментные зерна.
80.
Слайд 7981.
Слайд 80Ядра моноцитов разнообразной и изменчивой конфигурации: встречаются бобовидные,
подковообразные, редко - дольчатые ядра с многочисленными выступами и углублениями.
Гетерохроматин рассеян мелкими зернами по всему ядру, но обычно в больших количествах он
располагается под ядерной оболочкой. В ядре моноцита содержится одно или несколько маленьких
ядрышек.
Цитоплазма моноцитов менее базофильна, чем цитоплазма лимфоцитов. При окраске по
Романовскому-Гимзе она имеет бледно-голубой цвет, но по периферии окрашивается несколько
темнее, чем около ядра; в ней содержится различное количество очень мелких азурофильных зерен
(лизосом).
Имеются короткие канальцы гранулярной эндоплазматической сети, а также небольшие
митохондрии.
Моноциты относятся к макрофагической системе организма, или к так называемой мононуклеарной
фагоцитарной системе (МФС), объединяющей моноциты крови и макрофаги различных органов
(макрофаги альвеол легкого, костного мозга, лимфатических узлов, селезенки, гистиоциты
соединительной ткани, остеокласты, глиальные макрофаги ЦНС и др.).
Моноциты циркулирующей крови представляют собой подвижный пул относительно незрелых
клеток, находящихся на пути из костного мозга в ткани. В кровотоке моноциты циркулируют 12-32
ч, затем выселяются в ткани. Продолжительность жизни в ткани - в пределах 1 мес. При этом они
увеличиваются в размерах, появляется большое число лизосом, возникают рецепторы
иммуноглобулинов (антител), повышается фагоцитарная активность, клетки могут сливаться друг с
другом с образованием гигантских форм. Клетки способны синтезировать и выделять множество
веществ, влияющих на кроветворение, активность лейкоцитов, развитие воспалительной реакции и
др
82.
Слайд 81Строение моноцитов:
а - разновидности моноцитов по размерам и форме в мазке крови человека. Окраска по
Романовскому-Гимзе
1 - ядро;
2 - цитоплазма;
3 - эритроцит;
б - схема ультрамикроскопического
строения моноцитов :
1 - ядро;
2 - рибосомы;
3 – микроворсинки;
4 - лизосомы;
5 - комплекс Гольджи;
6 - митохондрии;
7 - пиноцитозные пузырьки;
в - электронная микрофотография
Увеличение 15 000
83.
Слайд 82Дифференцировка моноцита в макрофаг
I - моноцит;
II - дифференцирующийся макрофаг;
III, IV - зрелые макрофаги.
1 - ядро;
2 - рибосомы;
3 - микроворсинки и складки;
4 - лизосомы;
5 - комплекс Гольджи;
6 - митохондрии;
7 - пиноцитозные пузырьки;
- фаголизосомы
84.
Слайд 8385.
Слайд 84 ПАТОЛОГИЧЕСКИЕ ИЗМЕНЕНИЯ ЛЕЙКОЦИТОВПАТОЛОГИЧЕСКИЕ ИЗМЕНЕНИЯ ЛЕЙКОЦИТОВ проявляются:
1)нарушением их образования (лейкопоэза) в кроветворной ткани,
2) качественными изменениями,
3) количественными изменениями.
86.
Слайд 85Патологические формы лейкоцитов
Патологические формы лейкоцитов подразделяют на регенеративные(обнаруживаемые в
норме только в костном мозге) и дегенеративные(деструктивно измененные) формы.
Дегенеративные изменения лейкоцитов могут быть следствием прямого или
опосредованного повреждающего воздействия болезнетворных факторов на зрелые клетки
крови, а также дизрегуляции кроветворной функции костного мозга в результате патологии
гемопоэтического микроокружения и ранних клеток-предшественниц гемопоэза.
Признаки дегенерации в лейкоцитах могут обнаруживаться при инфекциях, воспалении, в
условиях экзогенной и эндогенной интоксикации, при ожогах, действии ионизирующего
излучения, недостаточности витамина В12и фолиевой кислоты, агранулоцитозе, лейкемоидных
реакциях, лейкозах, миелодиспластическом синдроме, на фоне терапии цитостатическими
препаратами, глюкокортикоидами и др.
Также дефекты морфологии лейкоцитов могут иметь наследственную природу. Примером
является аутосомно-доминантная аномалия Пельгера-Хьюэта, аутосомно-рецессивный
синдром Чедиака-Хигаси.
87.
Слайд 86Полисегментированные лейкоциты
88.
Слайд 87 Патологические и нормальные формы лимфоцитов имоноцитов:
1 - нормальный
узкоцитоплазменный лимфоцит;
2 - нормальный моноцит;
3 - пикноз ядра лимфоцита;
4 - вакуолизация ядра и
цитоплазмы моноцита;
5 - фрагментация ядра
лимфоцита и моноцита;
6 - микроформы лимфоцитов
89.
Слайд 88Патологические формы гранулоцитов:
1 - микроформы гранулоцитов;
2 - гигантский гиперсегментированный
нейтрофил;
3 - фрагментация ядра нейтрофила;
4 - вакуолизация ядра и цитоплазмы
нейтрофила;
5 - хроматинолиз ядра;
6 - рексис ядра;
7 - нейтрофия с токсогенной
зернистостью;
8 - тельца КнязьковаДеле;
9 - кариолизис;
10 - дегрануляция базофила
90.
Слайд 88 (а)91.
Слайд 89ТРОМБОЦИТЫ - КРОВЯНЫЕ пластинки
Кровяные пластинки, тромбоциты (thrombocytus), в свежей крови человека имеют вид мелких
бесцветных телец округлой, овальной или веретено-видной формы размером 2-4 мкм. Они
могут объединяться (агглютинироваться) в маленькие или большие группы. Количество их в
крови человека колеблется от 2,0×109/л до 4,0×109/л. Кровяные пластинки представляют собой
безъядерные фрагменты цитоплазмы, отделившиеся от мегакариоцитов - гигантских клеток
костного мозга.
Продолжительность жизни тромбоцитов в среднем 9-10 сут. Стареющие тромбоциты
фагоцитируются макрофагами селезенки. Усиление разрушающей функции селезенки может
быть причиной значительного снижения числа тромбоцитов в крови (тромбоцитопения). Для
устранения этого требуется операция - удаление селезенки (спленэктомия).
92.
Слайд 90Ультрамикроскопическое строение тромбоцита
(кровяной пластинки)
Тромбоциты в кровотоке имеют форму двояковыпуклого диска. При окраске мазков крови
азуром II-эозином в кровяных пластинках выявляются более светлая периферическая часть гиаломер и более темная, зернистая часть - грануломер, структура и окраска которых могут
варьировать в зависимости от стадии развития кровяных пластинок. В популяции тромбоцитов
находятся как более молодые, так и более дифференцированные и стареющие формы. Гиаломер
в молодых пластинках окрашивается в голубой цвет (базофильный), а в зрелых - в розовый
(оксифильный).
а - горизонтальный срез;
б - поперечный срез.
1 - плазмолемма с гликокаликсом;
2 - открытая система канальцев,
связанная с инвагинациями
плазмолеммы;
3 - актиновые филаменты;
4 - циркулярные пучки
микротрубочек;
4б - микротрубочки в поперечном
разрезе;
5 - плотная тубулярная система;
6 - альфа-гранулы; 7 - бета-гранулы; 8 - митохондрии; 9 - гранулы гликогена; 10 - гранулы
ферритина; 11 - лизосомы; 12 - пероксисомы
93.
Слайд 91Плазмолемма имеет толстый слой гликокаликса (15-20 нм), образует инвагинации с
отходящими канальцами, также покрытыми гликокаликсом. В плазмолемме содержатся
гликопротеины, которые выполняют функцию поверхностных рецепторов, участвующих в
процессах адгезии и агрегации кровяных пластинок.
Цитоскелет в тромбоцитах хорошо развит и представлен актиновыми микрофиламентами и
пучками (по 10-15) микротрубочек, расположенными циркулярно в гиаломере и
примыкающими к внутренней части плазмолеммы. Элементы цитоскелета обеспечивают
поддержание формы кровяных пластинок, участвуют в образовании их отростков. Актиновые
филаменты участвуют в сокращении объема (ретракции) образующихся кровяных тромбов.
В кровяных пластинках имеются две системы канальцев и трубочек, хорошо видных в
гиаломере при электронной микроскопии. Первая - это открытая система каналов, связанная,
как уже отмечалось, с инвагинациями плазмолеммы. Через эту систему выделяется в плазму
содержимое гранул кровяных пластинок и происходит поглощение веществ.
Вторая - это так называемая плотная тубулярная система, которая представлена группами
трубочек с электронно-плотным аморфным материалом. Она имеет сходство с гладкой
эндоплазматической сетью, образуется в комплексе Гольджи.
В грануломере выявлены органеллы, включения и специальные гранулы. Органеллы
представлены рибосомами (в молодых пластинках), элементами эндоплазматической сети,
комплексом Гольджи, митохондриями, лизосомами, пероксисомами. Имеются включения
гликогена и ферритина в виде мелких гранул. Содержимое гранул при активации пластинок
выделяется по открытой системе каналов, связанных с плазмолеммой
94.
Слайд 92Функция тромбоцитов
Основная функция кровяных пластинок - участие в процессе свертывания крови - защитной
реакции организма на повреждение и предотвращение потери крови. Разрушение стенки
кровеносного сосуда сопровождается выделением из поврежденных тканей веществ (факторов
свертывания крови), что вызывает прилипание (адгезию) тромбоцитов к базальной мембране
эндотелия и коллагеновым волокнам сосудистой стенки. При этом через систему трубочек из
тромбоцитов выходят плотные гранулы, содержимое которых приводит к образованию сгустка тромба.
Одной из функций тромбоцитов является их участие в метаболизме серотонина. Тромбоциты это практически единственные элементы крови, в которых, поступая из плазмы, накапливаются
резервы серотонина. Связывание тромбоцитами серотонина происходит с помощью
высокомолекулярных факторов плазмы крови и двухвалентных катионов с участием АТФ.
В процессе свертывания крови из разрушающихся тромбоцитов высвобождается серотонин,
который действует на проницаемость сосудов и сокращение гладких миоцитов их стенки.
Серотонин и продукты его метаболизма оказывают противоопухолевое и радиозащитное
действие. Торможение связывания серотонина тромбоцитами обнаружено при ряде заболеваний
крови - злокачественном малокровии, тромбоцитопенической пурпуре, миелозах и др.
95.
Слайд 93Адгезия
Вовлечение тромбоцитов в процесс гемостаза невозможно без их адгезии к поверхности.
Повреждение сосуда нарушает целостность эндотелиального слоя и приводит к экспозиции
нижележащего за эндотелием слоя молекул коллагена соединительной ткани. Тромбоциты
адгезируют к коллагену преимущественно через посредника, который называется фактором
Виллебранда (фон Виллебранда) – плазменный белок, секретируемый эндотелиальными
клетками и тромбоцитами. Этот белок связывается с экспонируемыми молекулами коллагена
и, изменяя свою конформацию, становится способным связывать тромбоциты. Таким образом,
фактор Виллебранда формирует своего рода мост между стенкой поврежденного сосуда и
тромбоцитами.
Связывание тромбоцитов с коллагеном запускает процесс выделения тромбоцитами
содержимого их секреторных везикул, содержащих различные химические агенты. Многие из
которых, включая АДФ и серотонин, затем действуют локально и индуцируют
многосторонние изменения в метаболизме, форме и поверхностных белках тромбоцитов, а
данный процесс называется активацией тромбоцитов. Некоторые изменения приводят к тому,
что новые тромбоциты начинают слипаться со старыми. И по принципу положительной
обратной связи осуществляется процесс агрегации тромбоцитов (слипания), которая вскоре
заканчивается формированием тромбоцтарного гвоздя (тромбоцитарной затычки/пробки –
platelet plug).
96.
Слайд 9497.
Слайд 95Свойства и функции тромбоцитов
Тромбоциты обладают следующими
Свойствами:
- способность к адгезии;
- способность к вязкому метаморфозу (комплексные изменения ,ведущие к истончению
мембраны и ее разрушению);
- способность к реакции освобождения;
- способность к агрегации.
Функции:
- запуск немедленного гемостаза за счет адгезии и агрегации тромбоцитов, что приводит к
формированию тромбоцитарной пробки
- местное выделение вазоконстрикторов для уменьшения кровотока в пораженном участке
- катализ р-ц гуморальной системы свертывания с образованием в конечном счете фибринового
сгустка
- инициирование репарации тканей
- регулирование местной воспалительной реакции и иммунитета
98.
Слайд 96Изменения показателя свертывания крови отмечаются при ряде заболеваний. Например,
усиление свертывания крови обусловливает образование тромбов в кровеносных сосудах,
например при атеросклерозе, когда изменены рельеф и целостность эндотелия. Уменьшение
числа тромбоцитов (тромбоцитопения) приводит к снижению свертываемости крови и
кровотечениям. При наследственном заболевании гемофилии имеют место дефицит и нарушение
образования фибрина из фибриногена.
99.
Слайд 97Норма тромбоцитов в периферической крови
Количество кровяных пластинок измеряется в тысячах на 1 микролитр крови. Для мужчин
нормой считают 200–400 тысяч Ед/мкл, а для женщин — 180–320 тысяч Ед/мкл.
В период менструации уровень может упасть до 75–220 тысяч Ед/мкл — это нормально.
Снижается показатель и во время беременности — приблизительно до 100–310 тысяч
Ед/мкл.
У детей нормальный показатель содержания тромбоцитов в крови зависит от возраста.
Например, у новорожденных он составляет 100–420 тысяч Ед/мкл, а у малышей от 2 недель
до 12 месяцев насчитывается 150–350 тысяч Ед/мкл.
У детей от 1 года до 5 лет нормальным считается количество — 180–380 тысяч Ед/мкл, а от
5 до 7 лет — 180–450 тысяч Ед/мкл.
Подсчет пластинок производится в лабораторных условиях тремя способами:
в счетной камере с использованием фазово-контрастного устройства,
в окрашенных мазках крови по Фонио и с помощью гематологических анализаторов.
В бланке результата анализа показатель обозначен как PLT или Platelets.
100. Вопросы для самоконтроля
1. Строение крови.2. Назовите форменные элементы крови, их функцию.
3. Строение и норма содержания в периферической крови эритроцитов.
4. Строение и норма содержания в периферической крови тромбоцитов.
5. Классификация лейкоцитов.
6. Строение, норма содержания в периферической крови эозинофилов.
7. Строение, норма содержания в периферической крови базофилов.
8. Строение, норма содержания в периферической крови моноцитов.
9. Строение, норма содержания в периферической крови нейтрофилов.
10. Строение, норма содержания в периферической крови Т-лимфоцитов.
11. Строение, норма содержания в периферической крови В-лимфоцитов.
12. Строение, норма содержания в периферической крови тромбоцитов.

Медицина
Медицина








